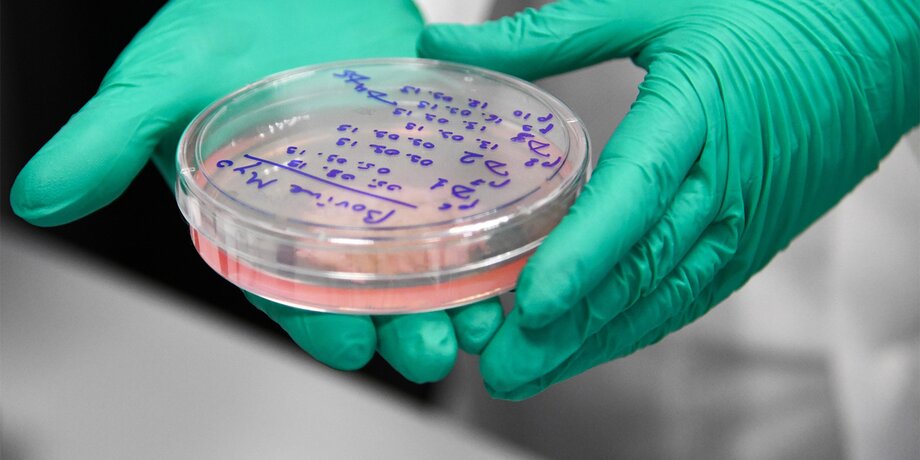

Оказывается, время синтетической пищи гораздо ближе, чем мы предполагали. Буквально на днях был сделан первый шаг, способный в буквальном смысле перевернуть мясную промышленность. Подробнее – в материале нашего научного обозревателя Николая Гринько.
Герои фантастических произведений, действие которых разворачивается в далеком будущем, чаще всего едят синтетическую пищу и рассказывают легенды о том, что когда-то люди питались настоящим мясом. Натуральную отбивную все еще можно достать, но стоить она будет целое состояние в межгалактической валюте. Нам всегда казалось, что все это дело очень отдаленного времени.
Да, сейчас ведутся какие-то эксперименты по изготовлению "мяса в пробирке", кое-кто из ученых даже поджаривает лабораторные образцы и пробует на вкус, но до промышленного изготовления еще так далеко, что даже задумываться об этом не стоит…

Сингапур официально одобрил использование в ресторанах искусственного куриного мяса, выращенного в биореакторах, став первой в мире страной, оформившей нормативное разрешение на такую пищу. Искусственная курятина производится без убоя птицы, она выращивается лабораторных условиях в виде культуры клеток.
Первым продуктом, официально допущенным к продаже, станут куриные наггетсы, которые будет производить американская компания Eat Jus. Клетки для продукта выращиваются в биореакторе объемом 1 200 литров, а затем комбинируются с растительными ингредиентами. Поначалу синти-наггетсы будут продавать лишь в одном ресторане, но со временем объемы производства увеличатся, а цены снизятся.
Есть все предпосылки к тому, что человечество обязательно начнет употреблять исключительно синтезированную пищу. Главная причина, конечно, в ограниченности сельскохозяйственных ресурсов на фоне растущего населения Земли. Мы не можем безгранично размножаться, поскольку животных и растений, которыми мы питаемся, на всех не хватит.
Еще одна очевидная причина – экономическая. Мы тратим огромные ресурсы на обработку земель, выращивание скота, борьбу с болезнями животных и растений, сбор урожая и еще многое-многое другое. Сельское хозяйство – невероятно дорогой и трудоемкий способ добывать еду, но другого у нас не было. Теперь же все расчеты показывают, что промышленное производство синтетической еды будет намного дешевле.

Но есть и еще одна, не столь очевидная причина. Имя ей – снижение биоразнообразия. Сегодня самое распространенное растение на Земле – пшеница, поскольку это основная сельскохозяйственная культура. Самая многочисленная популяция птиц на планете – это куры различных пород, поскольку их миллионами выращивают на птицефабриках. Примерно то же самое можно сказать про коров и свиней.
По некоторым данным, 60% млекопитающих всей планеты – это домашний скот, человечество составляет 36%, а дикие животные – всего 4%. Мы вырубаем леса, уничтожаем дикую природу и при этом старательно культивируем избранные виды. Если и дальше так пойдет, то у нас со временем останется десяток пород животных и примерно столько же видов растений. Биосфера Земли потеряет разнообразие. А это очень плохо для экологии: моносистемы хуже справляются с болезнями, накапливают негативные мутации и живут очень недолго.

А еще на сельское хозяйство приходится около 12% выбросов парниковых газов, и это без учета недавних сенсационных публикаций о том, что коровы сами по себе – постоянный и очень сильный источник метана.
В общем, синтез пищи – дело совершенно решенное, неясно только, когда именно наступит эта эпоха. Но первый шаг в этом направлении мы, как видите, уже сделали: пока в виде наггетсов из мяса, выращенного в пробирках. Кстати, было бы очень интересно попробовать, какие они на вкус. Хотя…








Собянин: более 3 тыс школьников из Москвы вышли в финал всероссийской олимпиады
Гринько Николай



























